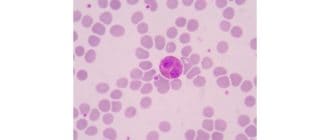

表皮水疱症は、熱、摩擦、擦り傷、擦り傷、または軽傷に接触すると、皮膚および粘膜に水疱を発生させる遺伝的状態の珍しい群である。 表皮水疱症(EB)は、ケラチンまたはコラーゲン遺伝子の欠損または突然変異によって引き起こされ、 […]
同誌に掲載された新しい研究によれば、食道癌患者は手術後数ヶ月間に症状の「クラスター」が異なることがあり、特定のクラスターを持つ患者はこの疾患による死亡リスクが高い可能性がある。 食道癌は、食道の癌として定義され、食道また […]
急性前立腺炎は前立腺の突然の炎症である。それは前立腺炎の一般的な問題である稀なタイプの前立腺炎です。 前立腺は、体の尿と精液を取り出す尿道を取り囲む小さな腺です。前立腺は精液に栄養を供給し、繁殖に重要な役割を果たします。 […]
免疫システムは白血球を使って細菌、ウイルス、および感染を引き起こす可能性のあるものと戦います。しかし、ただ一つの白血球タイプを使用するだけではありません。代わりに、いくつかのタイプの免疫系細胞が存在する。これらには好酸球 […]
アボカドは、科学的にはアボカドの木の実であると知られています。それはメキシコと中央アメリカのネイティブです。 一不飽和脂肪が豊富で、アボカドは滑らかでクリーミーな風合いを持っています。他のほとんどの果物よりも脂肪含量がは […]
喉の痛みは、通常は治療を受けなくなります。しかし、市販薬は喉の痛みを治療するのに必ずしも効果的というわけではなく、喉の痛みが良くなるには数日かかることがあります。エッセンシャルオイルは、喉の痛みを和らげる代替手段です。 […]
新しい研究によると、ラベンダー油やティーツリーオイルなどの精油に含まれる化学物質は、ホルモンの正常な機能を阻害し、妊娠前の男の子の男性性乳房炎と呼ばれる状態につながる可能性があります。 男性の女性化乳房は、男児が異常に高 […]
赤芽球性乾癬は、乾癬の攻撃的で炎症性の形態である。症状としては、身体の全面を覆う剥がしがあります。発疹はかゆみや激しく燃え、すぐに広がります。 Erythrodermic psoriasisは、しばしば不安定なプラーク乾 […]
腺癌は、体内または体外に物質を分泌する細胞である腺に形成される癌の一種です。 腺癌の見通し、治療および生存率は、腫瘍の位置、大きさ、段階、および個人の全体的な健康状態を含む個々の因子に依存する。 タイプ 腺癌は腺で始まり […]
閉経はホルモンの移行や出生率の低下など、さまざまな症状を引き起こす可能性があります。ホルモン療法を含むいくつかの薬が役立ちます。 しかし、ホルモン療法(HT)はいくつかの形態の癌に関連しており、多くの女性が人工ホルモンの […]
体内の循環赤血球数が減少すると貧血が起こります。これは、一般的な人口における最も一般的な血液疾患である。症状には頭痛、胸痛、淡い皮膚が含まれます。 現在、世界中で3百万人以上のアメリカ人と16億2000万人の人々に影響を […]
黒豆はマメ科に分類されます。黒い豆は、その硬い、殻のような外観のためにカメビーンとしても知られ、実際には、植物の食用種子です。 ピーナッツ、エンドウ豆、レンズ豆などの他のマメ科植物と同様に、黒豆はタンパク質や繊維の含有量 […]
私たちの大部分は、締めくくりの期限や楽しい夜のために、ある時点でエネルギードリンクを消費してきました。エネルギードリンクはしばしば無害であると認識されているが、以前に健康な男性が肝炎を発症して、あまりにも多くのエネルギー […]
ブラウン大学の研究者らは、高齢患者の間でホスピス使用率とICU利用率が過去10年間で増加していると報告している(JAMA)。著者らは、より遅いヘルスケアの移行、入院の繰り返しなど、積極的なケアは本当に患者とその家族が本当 […]
ナスは、ウイグナー、ガーデンエッグ、モルモット、メロンゲン、ブリンジャルとも呼ばれ、通常、卵のような形と鮮やかな紫色をしています。 それは繊維が豊富で、カロリーが低く、さまざまな栄養素を提供し、地中海の食生活に役立ちます […]
有望な結果は、ブラインド患者が、網膜下のマイクロチップで視力を回復したことを示していると、ドイツで行われたデバイスの第2回臨床試験の第1部によると、 この研究に関与した患者は、王立協会の議事録に掲載されており、網膜色素変 […]
酵素は人体の化学反応を促進します。それらは分子に結合し、それらを特定の方法で変化させる。彼らは何千もの他の役割の中で、呼吸、食物消化、筋肉、神経機能に不可欠です。 この記事では、酵素が何であるか、それがどのように機能する […]
誰かが健康的な食べ物を考えるとき、ゼラチンは心に浮かぶ最初のものの一つではないかもしれません。しかし、ゼラチンは、ちょっとした子供の頃のスナックや病院の定番ではありません。 この記事では、ゼラチンの予期せぬ健康上の利点に […]
時間が経つにつれて、糖尿病に起因する血糖値の上昇は、幅広い深刻な健康問題を引き起こす可能性があります。しかし、これらの健康問題には何が関与していますか、そして身体の器官はどのように影響を受けていますか?これらの影響を最小 […]
アボカドオイルは料理での使用が最もよく知られていますが、スキンケアにも役立ちます。このオイルは、多くのタイプのクリーム、モイスチャライザー、日焼け止めの成分です。 この記事では、アボカドオイルの肌へのメリットを探り、それ […]
線維筋痛は、筋肉に痛みや疲労を引き起こす複雑な障害です。この痛みは、首、肩、背中、臀部、腕、脚を含む身体の特定の優しい点にありがちであり、圧力がかかったときに起こります。 医師は線維筋痛の原因を本当に知っていません。すべ […]